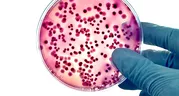

Safe2Eat
#Safe2EatEU a pour but de vous aider à mieux connaître la sécurité alimentaire en Europe et à prendre des décisions éclairées concernant les aliments que vous achetez, consommez et savourez chaque jour , sainement et en toute sécurité.
Thèmes de Safe2Eat
Qu’y a-t-il dans nos aliments?
Nous nous soucions, pour la plupart d’entre nous, de ce que contiennent nos aliments – lors des courses au supermarché, en cuisinant chez soi ou lors des repas entre amis ou en famille.
Alimentation et santé
Varier notre alimentation – en consommant beaucoup de produits frais ainsi que des aliments transformés et en utilisant différentes méthodes de cuisson – permet généralement d’équilibrer notre régime alimentaire et de contribuer à notre santé et à notre bien-être.
Manipuler les denrées alimentaires dans le respect des règles de sécurité
Vos aliments sont sûrs à la consommation lorsqu’ils sont frais et manipulés correctement. Les réglementations européennes et nationales fondées sur des données scientifiques aident les agriculteurs, les industriels, les restaurateurs ainsi que vous, les consommateurs, à faire en sorte d’assurer la sécurité alimentaire de vos repas quotidiens.
Pays participants
En savoir plus sur la sécurité alimentaire dans votre pays – pour trouver des informations précises sur ce qui se passe dans chacun de nos pays participants.
Boîte à outils
Notre boîte à outils fournit des ressources spécifiques à chaque pays – documents destinés à la presse, contenus visuels, publications sur les médias sociaux, etc. – sur une sélection de sujets relatifs à la sécurité alimentaire, à l’hygiène alimentaire, à la santé et à la nutrition.